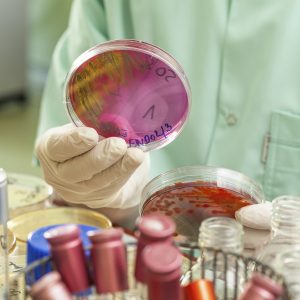

Cultural Considerations at the End of Life
Showing 28–36 of 46 results
-
Current Issues in Nutrition
Sold By: ALLEGRA Learning Solutions -
Depression: An Integrative Approach
Sold By: ALLEGRA Learning Solutions -
Diabetes in Pregnancy
Sold By: ALLEGRA Learning Solutions -
Domestic (Intimate Partner) Violence
Sold By: ALLEGRA Learning Solutions -
ECTOPIC PREGNANCY
Sold By: ALLEGRA Learning Solutions -
ELDER ABUSE AND NEGLECT
Sold By: ALLEGRA Learning Solutions -
Emerging Global Infectious Diseases
Sold By: ALLEGRA Learning Solutions